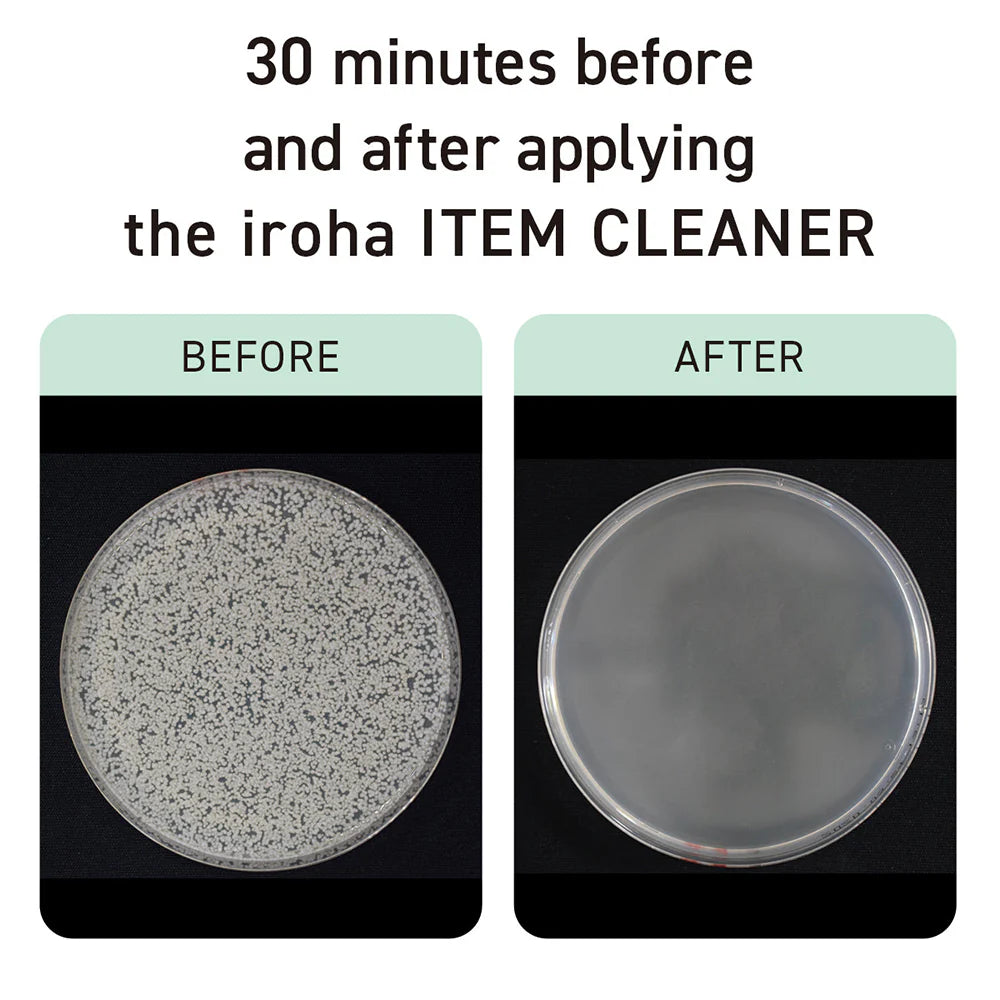
Iroha Foaming No Rinse Toy Cleaner

Iroha Foaming No Rinse Toy Cleaner
The Iroha Foaming No Rinse Toy Cleaner is a gentle, skin-safe foaming cleanser with silver ions that cleans and sanitizes silicone and other delicate pleasure products without the need for rinsing, making it perfect for at-home or travel use.
- Gentle, no-rinse foaming formula for easy toy cleaning
- Contains silver ions and mild ingredients to sanitize and remove residue
- Safe for silicone and skin with a mildly acidic, body-friendly formula
- Compact, portable design ideal for home or travel use
The Iroha Foaming No Rinse Toy Cleaner makes caring for your favorite pleasure products simple, gentle, and stress-free. Formulated with mild, skin-friendly ingredients and silver ions for antibacterial cleansing, this foaming cleaner helps keep your Iroha toys fresh and ready for use. The soft, airy foam glides easily over delicate materials like silicone, lifting away residue without irritation or harsh chemicals. Its mildly acidic balance makes it safe for both your skin and your toys, so you can feel confident using it before or after any self-pleasure session. Designed for convenience, the Iroha Foaming No Rinse Toy Cleaner requires no rinsing, just apply a pump of foam, wipe clean with a tissue, and you’re done. Its compact, travel-friendly bottle fits easily into a pouch or bedside drawer, making it perfect for daily use or discreet storage. Whether you’re unwinding at home or on the go, this easy-to-use, no-rinse formula ensures your favorite pleasure products stay clean, soft, and body-safe, so you can focus on enjoying the moment.
- Ingredients: Water, Butylene Glycol, Decyl Glucoside, Tea-Cocoyl Glutamate, Silver Oxide, o-Cymen-5-ol, Citric Acid, Sodium Citrate, Phenoxyethanol
U.S. Orders:
- All U.S. orders over $135 ship FREE!
- $10 flat rate shipping for standard sized products in the U.S
Shipping, as well as billing, is discreet and will not have Spectrum or any other adult company name visible.Because of mail delays due to COVID, international orders might take slightly longer than usual to arrive. We cannot offer any discounts or refunds for orders that do not arrive by a specific date. We apologize for any inconvenience, and appreciate your understanding!
Fast Shipping
when you spend $100.
Discreet Packaging
Choose options
The Iroha Foaming No Rinse Toy Cleaner is a gentle, skin-safe foaming cleanser with silver ions that cleans and sanitizes silicone and other delicate pleasure products without the need for rinsing, making it perfect for at-home or travel use.
- Gentle, no-rinse foaming formula for easy toy cleaning
- Contains silver ions and mild ingredients to sanitize and remove residue
- Safe for silicone and skin with a mildly acidic, body-friendly formula
- Compact, portable design ideal for home or travel use
The Iroha Foaming No Rinse Toy Cleaner makes caring for your favorite pleasure products simple, gentle, and stress-free. Formulated with mild, skin-friendly ingredients and silver ions for antibacterial cleansing, this foaming cleaner helps keep your Iroha toys fresh and ready for use. The soft, airy foam glides easily over delicate materials like silicone, lifting away residue without irritation or harsh chemicals. Its mildly acidic balance makes it safe for both your skin and your toys, so you can feel confident using it before or after any self-pleasure session. Designed for convenience, the Iroha Foaming No Rinse Toy Cleaner requires no rinsing, just apply a pump of foam, wipe clean with a tissue, and you’re done. Its compact, travel-friendly bottle fits easily into a pouch or bedside drawer, making it perfect for daily use or discreet storage. Whether you’re unwinding at home or on the go, this easy-to-use, no-rinse formula ensures your favorite pleasure products stay clean, soft, and body-safe, so you can focus on enjoying the moment.
- Ingredients: Water, Butylene Glycol, Decyl Glucoside, Tea-Cocoyl Glutamate, Silver Oxide, o-Cymen-5-ol, Citric Acid, Sodium Citrate, Phenoxyethanol
U.S. Orders:
- All U.S. orders over $135 ship FREE!
- $10 flat rate shipping for standard sized products in the U.S
Shipping, as well as billing, is discreet and will not have Spectrum or any other adult company name visible.Because of mail delays due to COVID, international orders might take slightly longer than usual to arrive. We cannot offer any discounts or refunds for orders that do not arrive by a specific date. We apologize for any inconvenience, and appreciate your understanding!
Fast Shipping
when you spend $100.
Discreet Packaging
The Iroha Foaming No Rinse Toy Cleaner is a gentle, skin-safe foaming cleanser with silver ions that cleans and sanitizes silicone and other delicate pleasure products without the need for rinsing, making it perfect for at-home or travel use.
- Gentle, no-rinse foaming formula for easy toy cleaning
- Contains silver ions and mild ingredients to sanitize and remove residue
- Safe for silicone and skin with a mildly acidic, body-friendly formula
- Compact, portable design ideal for home or travel use
The Iroha Foaming No Rinse Toy Cleaner makes caring for your favorite pleasure products simple, gentle, and stress-free. Formulated with mild, skin-friendly ingredients and silver ions for antibacterial cleansing, this foaming cleaner helps keep your Iroha toys fresh and ready for use. The soft, airy foam glides easily over delicate materials like silicone, lifting away residue without irritation or harsh chemicals. Its mildly acidic balance makes it safe for both your skin and your toys, so you can feel confident using it before or after any self-pleasure session. Designed for convenience, the Iroha Foaming No Rinse Toy Cleaner requires no rinsing, just apply a pump of foam, wipe clean with a tissue, and you’re done. Its compact, travel-friendly bottle fits easily into a pouch or bedside drawer, making it perfect for daily use or discreet storage. Whether you’re unwinding at home or on the go, this easy-to-use, no-rinse formula ensures your favorite pleasure products stay clean, soft, and body-safe, so you can focus on enjoying the moment.
- Ingredients: Water, Butylene Glycol, Decyl Glucoside, Tea-Cocoyl Glutamate, Silver Oxide, o-Cymen-5-ol, Citric Acid, Sodium Citrate, Phenoxyethanol
U.S. Orders:
- All U.S. orders over $135 ship FREE!
- $10 flat rate shipping for standard sized products in the U.S
Shipping, as well as billing, is discreet and will not have Spectrum or any other adult company name visible.Because of mail delays due to COVID, international orders might take slightly longer than usual to arrive. We cannot offer any discounts or refunds for orders that do not arrive by a specific date. We apologize for any inconvenience, and appreciate your understanding!
Fast Shipping
when you spend $100.
Discreet Packaging



























